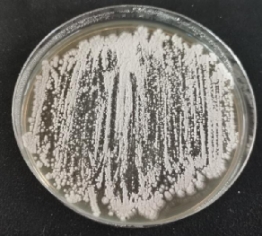

2021-03-15
土豆界的“刀疤哥”
本文作者:成人网站 马铃薯研究所 魏琪
马铃薯,俗称“土豆”,它的块茎含有大量的淀粉,能为人体提供丰富的热量,且富含蛋白质、氨基酸及多种维生素、矿物质,也因良好的口感深受人们的喜爱。
在这里想问大家一个小问题,“当大家在挑选土豆的时候,喜欢买什么品相的呢”?答案显而易见,大家当然都想选择“表皮光滑、干干净净的”,就如图1一样漂亮的土豆吧!然而,有一些土豆却没有这样光鲜亮丽的外表,其表皮上是一个又一个、甚至是连成片的“疤痕”(图2)。

图1 表皮健康的土豆(图片来自网络)

图2 表皮带有“疤痕”的土豆(作者拍摄)
是什么原因把漂亮的“土豆哥”变成了“刀疤哥”呢?其中一个最重要的原因就是“土豆哥”被细菌感染了,得了一种叫做“马铃薯疮痂病”的病!
马铃薯疮痂病是一种由链霉菌引起的病害,它在马铃薯块茎的表皮形成“痂状”病斑。这个病斑形成后是不可逆转的,它会永久地留在块茎的表面上。这种病害发生较轻时,一般只影响商品价值而不影响产量,因此很容易被农民忽视。然而,近几年,马铃薯疮痂病在我国的各大马铃薯主产区均有大面积发生,且发病程度逐年加重,继而造成的经济损失也是逐年增加。
图3 分离到的一种马铃薯疮痂病菌-Streptomyces scabies(作者拍摄)

图4 马铃薯疮痂病田间发病严重(图片来源于网络)
也许您会问,这种病害不能用农药防治吗?这个问题,截至目前的研究结果很难给您一个准确的回答。该病害防治难度之高是很难形容的,原因如下:
其一,马铃薯疮痂病发病规律至今还在探索中。
其二,引起该病害的病原菌种类多,各自特性复杂。
其三,该病害的致病菌---链霉菌对环境的适应性很强,一旦在土壤定殖可以存活多年。在北方,该致病菌能够在土壤中越冬。
其四,马铃薯疮痂病菌自主运动性差,但是它们可以随着水流、风雨、土壤、带病种薯等进行远距离传播,甚至风卷起带菌土壤形成的灰尘都可能形成传播。
其五,链霉菌对化学药剂的耐性相对较强,造成药剂防效低和稳定性差。
最后,至今还未筛选到对马铃薯疮痂病免疫的马铃薯品种资源。
讲解到这里,您一定很困惑,咱们拿这“马铃薯疮痂病”就真的没法子了吗?我想说,虽然我们还未找到完美的抗病品种和防治药剂,但是,我们还是要对这个病害的发生进行干预,尽可能降低它们对马铃薯生产造成的负面影响。
要如何干预,那一定是预防为主!首先,我们应该对马铃薯种植的地块进行3年以上的有效轮作,避免在疮痂病发病严重的地块种植马铃薯。其次,通过良好的栽培技术手段,合理水肥,提高马铃薯植株自身的“免疫力”,从而提高块茎的抗病性。再次,可施用生物菌肥或菌剂,通过丰富土壤内微生物种群多样性、竞争生长等方式降低该病原菌在土壤中的数量。最后,提醒大家,切不可在土壤内施用危险的高毒性化学药剂来防治马铃薯疮痂病,污染土地,祸及人类,得不偿失!
主办单位:成人网站-成人网站最新不迷路永久导航站 备案序号:黑ICP备11000329号技术支持:成人网站 农业遥感与信息研究所